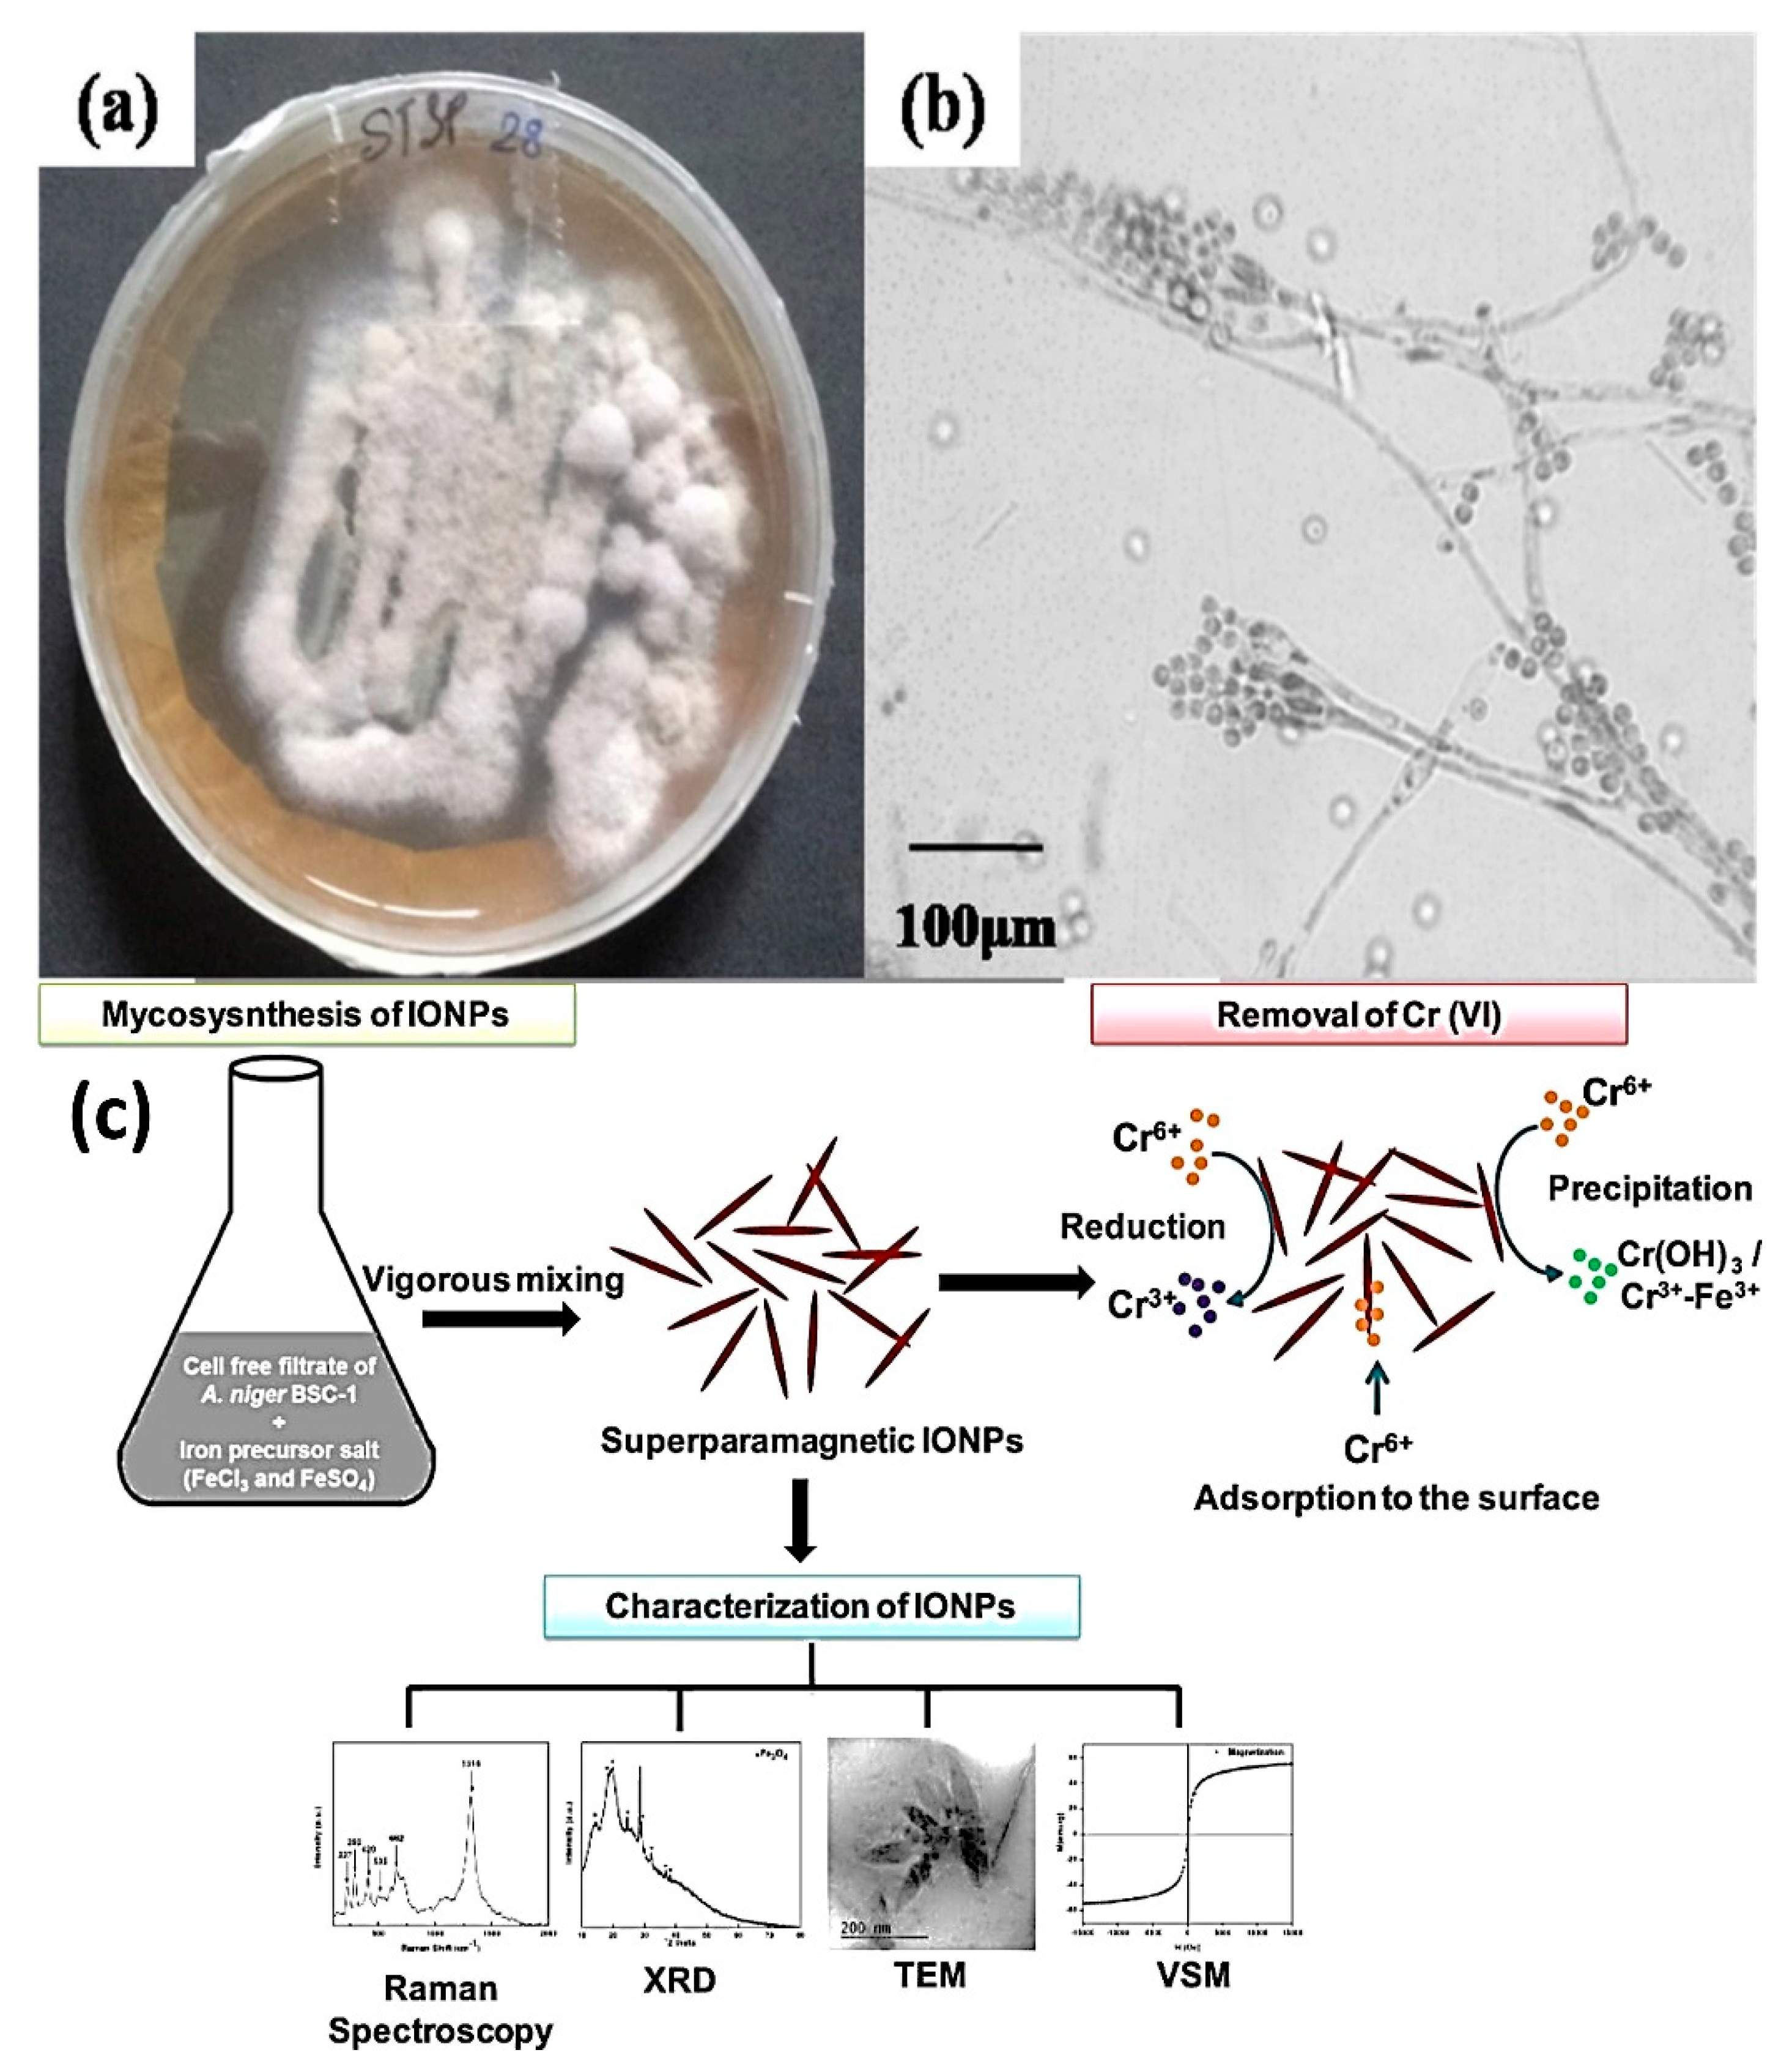
Nanomaterials 12 04187 g004 Nanomaterials 12 04187 g004

Abstract
Water scarcity due to contamination of water resources with different inorganic and organic contaminants is one of the foremost global concerns. It is due to rapid industrialization, fast urbanization, and the low efficiency of traditional wastewater treatment strategies. Conventional water treatment strategies, including chemical precipitation, membrane filtration, coagulation, ion exchange, solvent extraction, adsorption, and photolysis, are based on adopting various nanomaterials (NMs) with a high surface area, including carbon NMs, polymers, metals-based, and metal oxides. However, significant bottlenecks are toxicity, cost, secondary contamination, size and space constraints, energy efficiency, prolonged time consumption, output efficiency, and scalability. On the contrary, green NMs fabricated using microorganisms emerge as cost-effective, eco-friendly, sustainable, safe, and efficient substitutes for these traditional strategies. This review summarizes the state-of-the-art microbial-assisted green NMs and strategies including microbial cells, magnetotactic bacteria (MTB), bio-augmentation and integrated bioreactors for removing an extensive range of water contaminants addressing the challenges associated with traditional strategies. Furthermore, a comparative analysis of the efficacies of microbe-assisted green NM-based water remediation strategy with the traditional practices in light of crucial factors like reusability, regeneration, removal efficiency, and adsorption capacity has been presented. The associated challenges, their alternate solutions, and the cutting-edge prospects of microbial-assisted green nanobiotechnology with the integration of advanced tools including internet-of-nano-things, cloud computing, and artificial intelligence have been discussed. This review opens a new window to assist future research dedicated to sustainable and green nanobiotechnology-based strategies for environmental remediation applications.
1. Introduction
In recent decades, the advancement in the field of nanoscience and nanotechnology has led to improved treatment procedures for wastewater. The various nanotechnological-based pathways have been proven to be more effective than the traditional treatment techniques [1]. Nanoparticles (NPs) are smaller in size, have higher chemical characteristics, and are known to have a broad surface area-to-volume ratio. Traditionally, the NPs were synthesized using physical and chemical methods. These methods involved the application of hazardous materials, sophisticated machinery, and high-end equipment. This made the process of synthesis expensive, and difficult, and had a detrimental effect on the environment [2]. SSF slow filters accompanying biofilms with specific bacterial inoculum in the removal of biologically originated pathogens from streams, rivers, or lakes water bodies for beneficial purposes in agriculture and domestic use [3,4]. To overcome these downsides a significant shift towards a more feasible and environmentally friendly, microbial-based green NT is taking better shape. Green synthesis, as part of bio-inspired procedures, offers consistent and sustainable methods for the biosynthesis of NPs. This field is developing enormously and new methods in this field are constantly being designed to improve the existing properties of NPs [5].
Through a straightforward and eco-friendly process, a porous hierarchical based membrane was produced using a superior nanotechnological technique, demonstrating excellent flux and separation properties for oil/water emulsions, and dye removal was accomplished through photodegradation and adsorption. These nanomembranes exhibits anti-oil/dye/microorganism-fouling potential and these membranes efficaciously separates complex wastewater [6,7]. A hierarchical, fluorine-lose, and robust superhydrophobic membrane was constructed using electrospinning, rapid deposition, and soaking. The membrane had good self-cleaning, superhydrophobic, and oil/water separation capabilities [8]. Electro spun fiber membranes have overcome the drawbacks of traditional wastewater treatment methods, such as high energy consumption, low efficiency, and difficulty recycling. By combining pre- or post-functionalization methods with electrospinning, nanofibers can be produced with an ion-exchange functionality [9]. Microorganisms are imperative nano-factories capable of gathering and detoxifying heavy metals (HMs) [6]. They consist of a variety of reductase enzymes that help in the reduction of metal salts to NPs. The synthesis of green nanomaterials (NMs) from microorganisms has paved a path toward the eco-friendly remediation of pollutants. For example, the iron NPs extracted from Ageratum conyzoides are used in the remediation of wastewater due to their redox potential. They also react with water, provide magnetic susceptibility, and are non-toxic [10].
Similarly, membrane-associated NMs are also an effective method for effluent removal. They benefit by improving the membrane permeability, mechanical and temperature strength, resistance, and various functioning for the degradation of pollutants [11]. Nano-catalysts are well known for their role in the enhancement of degradation reactions. The photocatalytic nanofiber-based membranes are antimicrobial, cost effective and have application in micropollutants degradation with removal of harmful organism that consequently results in reduction of fouling of membrane [12]. Au/TiO2 photocatalyst treats Lomefloxacinin antibiotic contaminated wastewater [13].
Apart from membranes and nano-catalysts, metal-organic frameworks (MOFs) are active in the removal of HMs from wastewater. The coordination of organic ligands with precursors of metal ions leads to the synthesis of these MOFs [14]. The presence of functional groups with metal acts as a hindrance to the organic ligand. This reduces the steric hindrance and helps in the synthesis of extracellular green metal NPs. The NMs synthesized by this method are of more importance because they replace the need for expensive complex downstream processing steps [15]. It makes the recovery of extracellular NPs much easier. Biogenic NPs and nanomachinery designed through the microbial cells, either directly or their byproducts, e.g., cell proteins, and metabolites, are used to synthesize NPs for the bioremediation of the toxic pollutants from wastewater [16]. The green chemistry methods for the of NPs synthesis involve the use of live microbial cells be an innovative and effective tool in bio-nanotechnology.
The biogenesis of the NPs is eco-friendly, sustainable and cost-effective results highly efficient and productive products [17]. Such NPs possess significant sorption and catalytic efficiency and reduce the procedure cost for large-scale treatment of water bodies. In recent decades, different methodologies for the bioaugmentation, immobilization, and entrapment of microbial cells NPs showed highly effective and increased reaction rate bioremediation processes, e.g., such as metal oxides NPs, biopolymer-coated metal NPs, nanocomposites [18,19].
Wastewater is contaminated from different sources as explained in Figure 1. The different sources of contaminants in the wastewater system In natural remediation microbial cell and their consortium play an essential role to naturally metabolizing these toxic pollutants into the less toxic form, e.g., the saprophytic nature of fungi [20]. Thus, researchers have focused on microbes having bioremediation and bioconversion properties. Furthermore, lots of work such as bioreactor systems with the integration of NT, NPs entrapped catalytic membrane bioreactors, microbial fuel cells (MFCs), aerobic digesters, and nanofibrous matrix have been done in the past few years to significantly improve the efficiency of remediation of pollutants from the wastewater [21,22,23]. Overall, green NPs are a great alternative to the existing ways of NPs synthesis.
Figure 1.
The different sources of contaminants in the wastewater system [24].
In this review article, the latest advances, and innovations in the production of metal NPs using green synthesis by different groups of microorganisms and the application of these NPs in wastewater treatment sectors are discussed. We have also focused on removing dyes and pharmaceutical pollutants from the wastewater using such green or biogenic NPs. The review article also discusses the advanced integrated methodologies, major challenges, and the future prospects for improving the efficiency of removal of such pollutants from wastewater.
2. Nanotechnological Approaches for Wastewater Treatment
Clean and safe water is a fundamental human need for the multi-faceted development of society and a thriving economy. Measures are being taken to reduce this existing situation. Wastewater generated from domestic as well as industrial sources is both equally decremental to the environment [25]. To combat this issue mostly chemicals are employed which can have to the already growing concern over wastewater treatment. The treatment procedure should be effective, environmentally friendly, and conveniently cost-effective. Nanomaterials are known to be successful in the removal of various pollutants from wastewater [26]. This includes HMs organic and inorganic solvents, color as well as biological toxins, and pathogens. In recent years, NT has become a sustainable and eco-friendly approach for the treatment of water and other environmental remediations [2]. Using this system physiochemical and structural modification of the commonly used materials has been done for the efficient adsorption, degradation, and removal of toxic pollutants from the water bodies.
A wide range of engineered NMs and devices have been designed at a molecular and atomic level such as biosorption, dendrimers, nano-filters, and photocatalysis, thereby improving the efficiency of the water treating systems [27]. Besides that, different types of composite and integrated treating systems or filters consist of chemical and biogenic NPs, e.g., metallic, bimetallic NPs, mixed oxides, zeolites and carbon nanotubes/wires (CNT/Ws) are designed to increase the surface to volume ratio, better reactivity and neutralization of the toxicants with significant recovery rate [28]. The use of NT/NPs involves using nanomembranes to soften the water and eradicate biological and chemical contaminants as well as other physical particles and molecules. In this regard, nanobiotechnology has emerged as a subsidiary field focusing on the use of microbes and their active catalytic molecules as bio-nanomachinery for the synthesis and entrapment of NPs for bioremediation.
Microbes such as bacteria, fungi, algae, and their enzymes are used for the bioremediation of several toxic pollutants in wastewater (Figure 2). Previous studies reported the presence and decontamination of synthetic dyes in the effluents and their combinatorial treatment through physical, chemical and biological approaches with novel technology [29]. The application of microbes is considered a sustainable and renewable resource that is easy to cultivate, and cost-effective technology for large-scale production [30]. The NPs produced by microbes or biogenic NPs effectively degrade and remove HMs, toxic dyes, pharmaceuticals, and other emerging contaminants released by industrial, agricultural, and municipal waste in the water bodies (Table 1). The scope of use NPs in wastewater treatment is just not limited to the removal of chemical and HMs pollutants however, it is also promising for the early detection of the pathogen, toxicants and disinfection by-products (DBPs) by sensing technology [31]. So, it is thought that NT could offer affordable and accessible clean water solutions to the world’s most vulnerable populations.
Figure 2.
Mechanism of biosynthesis of microbial nanoparticles and their analysis for treatment [39].
Table 1.
Bio-nanoparticles for removal of wastewater pollutants.
Table 1.
Bio-nanoparticles for removal of wastewater pollutants.
| Microorganisms | Biosynthesized NPs | Pollutant | Size Range (nm) | Characterization | Removal Efficiency | Mechanism of Pollutant Removal | References |
|---|---|---|---|---|---|---|---|
| Heavy metals | |||||||
| Manglicolous fungi | Iron oxide nanoparticles | Cr (VI) | 2–16 | UV-vis spectroscopy, FTIR spectroscopy, FESEM-EDX, TEM-EDX, XRD analyzer, VSM | >90% | Chemisorption | [32] |
| Aspergillus niger BSC-1 | Iron oxide NPs | 20–40 | UV-vis spectroscopy, ATR-FTIR spectroscopy, Raman spectroscopy, XRD, TEM, FESEM, zeta sizer, VSM | >99% | Adsorption and redox reactions | [33] | |
| Aspergillus terreus S1 | Magnesium Oxide NPs | 8.0–38.0 | UV-vis spectroscopy, FTIR spectroscopy, TEM, SEM-EDX, XRD, DLS | 97.5% | Precipitation and adsorption | [34] | |
| Marinobacter sp. MnI-79 | Manganese oxide NPs | Ag+ | - | XPS, surface analyzer | 95% | Electrostatic attraction and redox reactions | [35] |
| Streptomyces thermolineatus | Iron Oxide magnetic NPs | Cu | 22 | UV-vis spectroscopy, FTIR spectroscopy, SEM, TEM, XRD, thermogravimetric analysis, vibrating sample magnetometer, dynamic light scattering. | 85% | Interactions between electrostatic attraction, surface complexation, and coordination | [35] |
| Pseudomonas aeruginosa JP-11 | Cadmium Sulphide NPs | Cd(II) | 20–40 | UV-vis spectroscopy, FTIR spectroscopy, XRD, FESEM, TEM, AAS | 88.66% | Adsorption | [26] |
| Spirulina plantesis | Palladium NPs | Pb | 10–20 | UV-vis spectroscopy, XRD, FTIR, TEM | 90% | Adsorption | [36] |
| Aspergillus tubingenesis STSP 25 | Iron Oxide NPs | Pb(II) | 73.05 | UV-vis spectroscopy, Zeta analyser, DLS, FTIR, TEM-EDX, XRD, SQUID-VSM | 98% | Adsorption | [32] |
| Ni(II) | 96.45% | ||||||
| Cu(II) | 92.19% | ||||||
| Zn(II) | 93.99% | ||||||
| Dyes | |||||||
| Shewanellaoneidensis | Magnetite/reduced graphene oxide nanocomposite | Methylene blue | 11.0 | TEM, XRD, FTIR spectroscopy, XRP spectroscopy, vibrating sample magnetometry | 100% | Electrostatic attraction | [37] |
| Caldicellulosiruptorsaccharolyticus | Palladium NPs | Methyl orange and Diatrizoate | 10–20 | AAS, SEM, TEM-EDS | 100% | Reduction | [37] |
| Bacillus marisflavi TEZ7 [38] | Silver NPs | Direct Blue-1, Methyl Red & Reactive Black 5 | 11.20–39 | FTIR Spectroscopy, XRD, TEM, SEM, EDS | 54.14–96.92% | Photocatalytic degradation | [38] |
| Bacillus paralicheniformis, Bacillus pumilus, Sphingomonaspaucimobilis [39] | Silver NPs | Malachite green | 4–20 | XRD, TEM, FTIR spectroscopy | >90% | Adsorption | [39] |
| Spirulina plantensisn | 17.9 | UV-vis spectroscopy, XRD, TEM, FTIR spectroscopy | 88% | Biosorption | |||
| Anabaena variabilis [39] | 26.4 | 81% | |||||
| Pseudochrobactrum sp. C5 | Zinc Oxide NPs | Methanol blue and reactive black 5 | 90–110 | FTIR spectroscopy, XRD, FESEM | >90% | Catalytic degradation | [39] |
| Pharmaceutical and Hospital wastewater contaminants | |||||||
| Shewanellaoneiedensis MR-1 | Bio-Palladium NPs doped with Au(0) | Diclofenac | - | - | 43.8 ±5.5% | Catalytic degradation | [40] |
| Pseudonomas putida | Manganeese Oxide NPs | Estrone and 7α-ethinylestradiol | - | TEM-EDS, HPLC-MSMS | 100% | Absorption and oxidation | [41] |
| Desulfovibrio vulgaris | Platinum NPs | 17-β estradiol | - | TEM | 94% | Catalytic reduction | [39] |
| Sulfamethoxazole | 85% | ||||||
| Escherichia coli | Biogenic Palladium NPs | Ciprofloxacin | 10–30 | SEM, EDXA, XPS | 87.70% | Reductive degradation | [38] |
NPs are synthesized using metabolites and cell components of microbial cells, including bacteria, fungi, actinomycetes, and microalgae, by activating or stimulating intracellular or extracellular pathways and used in wastewater treatment [42]. Fungus like Aspergillus tubingensis, Avicennia officinalis, Chlorella vulgaris are already used in the synthesis of iron NPs. The microbial cell enzymatic machinery reduced the entrapped metal ions and macromolecules accumulated on the cell surface or intracellular regions into NPs [43]. The biogenesis of NPs required additional downstream treatments for the purification and isolation of NPs, e.g., lysis of cells by ultrasonic, irradiation, flocculation, and rectification of NPs (Figure 3). In some cases, the metal resists proteins exhibited the reduction and capping of NPs to overcome the aggregation of NPs and enhance their stability for a prolonged incubation period. Researchers have shown the bioreduction and capping of potassium permanganate (KMnO4) into manganese dioxide (MnO2) NPs using Saccharomyces cerevisiae cellular machinery [44]. Subsequently, Silver NPs (AgNPs) were synthesized from cell-free extracts of different microbial strains, i.e., Bacillus paralicheniformis, Bacillus pumilus and Sphingomonas paucimobilis. The microbial enzymes reductase and bioactive metabolic peptides assist the stabilization of NPs, subsequently biosynthesized AgNPs display up to 90% efficiency for the removal of dye from wastewater [45]. Likewise, the biosynthesis of chromium NPs (CrNPs) was done by the Cr-resistant Bacillus subtilis isolated from the electroplating effluent waste. These CrNPs exhibited antipathogenic activities against Gram-negative and positive bacteria strains, i.e., Staphylococcus aureus and Escherichia coli [46].
Figure 3.
Biogenic Nanoparticles and their application in environment and agriculture (top) the bioremediation approach for the removal of toxic pollutants from the environment (bottom) [47].
2.1. Removal and Recovery of Heavy Metals
Microbes aids the treatment of multiple pollutants through doping of nanoparticles to improvise their action of biological process or bioremediation during the treatment. However, toxicity of nanoparticles is an issue. Therefore, to address the same nontoxic nanomaterials perhaps which increases microbial application in wastewater treatment must be used [48]. In absence of microbial support, synthesis of nanoparticles requires intensive energy, costlier and produces toxic chemicals but nanoparticles synthesized through in microbial system are energy intensive, cost effective, biocompatible, and ecofriendly. The wide microbial range of fungal, bacterial, viral and algal strain’s carbohydrates, proteins, and enzymes acts as capping agents and surfactants and shows capability to synthesis metal oxide, sulfide, metallic and nonmetallic nanoparticles in which these nanoparticles act as effective adsorbent for the bioremediation of wastewater pollutants and treatment [49]. The recent field of nano bioremediation or green synthesis of nanoparticles supports the treatment of wastewater from the contaminated areas through biogenically produced nanoparticles or materials synthesized from microbiological sources of nano size. Nano bioremediation is an economic and ecological approach and it has an advantage over chemical based synthetic methods due to the larger surface area, and volume ration concept, low size of the material for the reactions. economic and ecological aspects. The studies report the consequences and hazardous impact of heavy metals and metalloids which could be treated through biogenic nanoparticles [50]. The HMs can be easily removed from the wastewater using NM adsorbents. They have large specific surface areas with enhanced active sites which helps in better adsorption of contaminants [51]. Among the various water contaminants, HMs are a major environmental concern and the most dangerous, as they are highly toxic even in dilute concentrations, non-biodegradable, and accumulate throughout the food chain, destroying aquatic life and posing serious threats to human health [52]. HMs usually enter the food chain through aquatic floor and fauna. Plants tend to absorb heavy metals dissolved in water, and those metals accumulate in their roots and then move to edible parts like fruits and vegetables [53]. The terrestrial region of the sedimentary is rich in different metallic and non-metallic elements. However, the higher concentration of HM such as Cr, Cd, Ag, Pb, Cu, Ni, and Zn in water bodies causes pollution and physical-chemical changes. A higher level of HMs in water bodies causes detrimental effects in aquatic and terrestrial organisms, such as mutation, genotoxicity, generation of free radicals, oxidative stress, deactivation of enzymes or cellular machinery, and cell necrosis [17]. In the advanced approaches, the removal of HMs on the large surface area can be detected, adsorbed, and immobilized as contaminants by NMs. Nanomaterial adsorbents have many unique properties, such as nano-size, large surface area, highly reactive, strong solution mobility, strong mechanical property, porosity, hydrophilicity, dispersibility, and hydrophobicity characteristics [54]. Various types of NMs, such as bio sorbents, graphene, activated carbon, and magnetic NPs, have been investigated as effective adsorbents to remove heavy metal ions from raw wastewater. At the nanoscale, NMs often exhibit some special properties, such as a surface effect, a small size effect, a quantum effect, and a macro-quantum tunnelling effect [55]. These properties contribute to its extraordinary capacity for adsorption and reactivity, which are favourable for the removal of heavy metal ions. Carbon nanotubes (CNTs) have been extensively investigated over the last few decades and are reported to exhibit many outstanding properties, including optical, electronic, vibrational, mechanical, and thermal properties. In another research copper, NPs were synthesized from Escherichia sp. SINT7 [51]. These NPs were copper resistant. The use of Pseudoalteromonas sp. CF10–13 in the preparation of NPs provides an eco-friendly method for biodegradation. NPs having biosorption activity effectively interact with the HMs and form chelating compounds for their removal from contaminated sites [17].
Overall, the use of microbes to synthesis NT/NPs from microorganisms is effective in the removal of lead from contaminated wastewater. There are many methods and several organisms that are known to remove specific metals from wastewater. Some of them are discussed below.
(a) Removal of Chromium
The presence of chromium (Cr) in industrial effluents has become a major problem worldwide, as hexavalent chromium is highly toxic to animals due to its ability to generate reactive oxygen species in cells [56]. The trivalent state of chromium, on the other hand, is significantly less toxic and serves as an essential element in trace amounts. When industries such as electroplating, tannery, dyeing and others release their effluents into water bodies, hexavalent chromium enters the food chain and, consequently, reaches humans in a biomagnified form. In water bodies, Cr contamination and toxicity are the significant HM pollution challenge faced by researchers in terms of their mitigation [57]. Cr occurs most commonly in the trivalent/Cr(III) and hexavalent/Cr(VI) states. While the trivalent state of chromium is an important trace element, its hexavalent state is non-essential and toxic to animals and can cause dermatitis, lung cancer, kidney and gastric damage, and respiratory tract and eye irritation. Continued accumulation of toxic Cr(VI) along food chains often leads to biomagnification, putting humans at great risk. In one study, the biosynthesis of super-magnetic iron oxide NPs using the fungal strain Aspergillus niger BSC-1 has an extraordinary Cr(VI) removal efficiency [58]. This results in up to >99% selective removal of Cr(VI) ions by microfabricated NPs (Figure 4). Likewise, magnesium oxide NPs (MgO NPs) synthesized using Aspergillus terreus S1 were shown to significantly remove the Cr(VI) ion, i.e., 97.5% of wastewater. The conventional chemical reduction method comprises two steps—the reduction of Cr(VI) to Cr(III) by a reducing agent, at acidic pH, and the precipitation of Cr(III) as an insoluble hydroxide at alkaline pH. The chemical reductant can be any sulfur-based or iron-based salt [59]. These two steps can be combined into a single step by the electrochemical addition of a ferrous ion, rather than the addition of a ferrous salt (FeSO4 or FeCl2), which requires the use of an acidic and alkaline pH, making it a two-step process.
Figure 4.
(a) This represents Manglicolous Fungal colony (b) Manglicolous fungi’s Compound microscopic image [60] (c) Desorption and reusability study, like efficiency of different regenerative solution for desorption of Cr, regeneration study. Reprinted/adapted with permission from Ref. [60]. 2022, Elsevier B.V.
Adsorption is the most effective and economical solution for Cr(VI) remediation, especially if it is associated with adequate adsorbent regeneration. regeneration. In another system, the bio electrochemically active film of the Rhizobium-MAP7 strain helps in the detection and effective removal of Cr(VI) ions in the water system, is highly supported and recommended [61]. Another commonly used method involves the adsorption of Cr(VI) on various surfaces like titanium dioxide (Ti2O), goethite, activated carbon, zeolites and more. In some cases, reduction to Cr(III) may occur. Biosorption is a subdivision of adsorption, in which Cr(VI) is adsorbed on biomaterials found in abundance in nature, such as microbial biofilms. Adsorption is considered an effective method due to its low initial cost, flexibility in design and ease of operation. Furthermore, adsorption does not involve the formation of secondary residues such as sludge [62].
By implanting carbon nanofiber (CNF) anodes containing alumina (AA)/nickel (Ni) NPs in the double-chambered microbial energy component framework, the Cr(VI) has also been successfully removed, achieving power age *1540 mW/m2 [38]. However, for the hexavalent Cr, i.e., Cr (VI), the MFC system with the granulated activated carbon (GAC) filters with biogenic palladium NPs (Bio-PdNPs) significantly improved the Cr(VI)-removal and efficiency of the MFC [63]. In recent studies, Shewanella oneidensis was used for the Bio-PdNPs synthesis at the control parameter, these Bio-PdNPs with small dimensions act as a super catalyst and absorbent material for the complete reduction and removal of Cr(VI) from contaminated solution within a short period of 10 min up to five-time usage. Subsequently, the biogenic silicon NPs synthesized using the plant Equisetum arvense, i.e., green source to synthesize Si NPs (GS-SiNPs) as active adsorbent material for the significant removal of Cr (VI) from contaminated sites.
(b) Removal of Lead
An enormous increase in the application of various heavy metals including lead for commercial and non-commercial purposes has also led to their enhanced occurrence in the effluents from industries and domestic discharge creating substantial environmental concerns. Exposure of lead in the form of pipe corrosion, faucets, household plumbing systems, old paints, mining, smelting, battery manufacturing, and other industrial and urban waste causes lead to enter the water cycle [64]. Lead (Pb) is another toxic HMs predominantly present in industrial effluents and wastewater systems. Though it is present in a small amount in the earth’s crust, it is also released by anthropogenic activities such as mining, industrial operations, and fossil fuel burning. It has no biological role to play and it causes potential health risks among individuals, hence considered a priority metal of public health significance [52]. For Pb removal, sodium cations (Na+) are considered to have better exchangeability than HM. The pores present on the adsorbent surface help in making the significant area available for adsorption, and the diffusivity of the heavy metal ions based on pore size plays a controlling parameter undeciding the efficacy. The biosynthesised Palladium NPs (Pd NPs) of 10–20 nm dimension using algal strain Spirulina plantensis have been reported to possess 90% removal efficiency of Pb from contaminated sites under comprehensive physiological stress. However, the Iron oxide NPs (FeO2 NPs) bio-fabricated by using the fungus Aspergillus tubingensis demonstrated > 90% removal of not only Pb (II) but also other heavy metals, i.e., Ni (II), Cu (II), and Zn (II) from the contaminated sample. This approach also allows five times recyclability of the NPs used for remediation purposes.
(c) Removal of Mercury
Mercury (Hg) is also a HM with priority metal of public health significance mostly found in the aquatic system and effortlessly enters the food chain by sea food. Therefore, effective removal and remediation of the Hg from the wastewater have been done by the different approaches and different NPs at variable concentrations. For the removal of Hg, a hybrid catalytic membrane biofilm reactor (HCMBR) containing microflora such as Azospirillum, and Delftia were designed and evaluated as an effective system efficiently up to achieving 68.8 and 81.7%. In another study, the potential of biogenic selenium NPs (BioSeNPs) was investigated for the immobilization of Hg [25]. The study found that the salinity of the system along with the NPs aggregation resulted in reduced immobilization efficiency of Hg ion on the matrix. However, BioSeNPs coated with microbial biofilm on porous quartz resulted in enhanced retention and facilitated immobilization of Hg ions from the site contaminated with mercury selenide (HgS).
The effective and efficient removal of the toxic Hg(II), Ag-NPs embedded polyethylene glycol (PEG) nanocomposite functionalized by citrate was designed. This approach exhibited the potential for the accurate detection and removal of Hg2+, and excellent photocatalytic properties [38]. A cost-effective nanocomposite consisting of an Ag-Cu-dextran sensitized system with excellent photocatalytic properties can also be used for the selective and sensitive detection of Hg in wastewater. Biogenic Fe3O4 NPs of size 20 nm to 30 nm synthesized using the leaf extract of Thymus schimperi have exhibited significant removal of Hg (II) and can be reused without any significant loss of removal efficiency [65].
(d) Removal of Cadmium
Cadmium (Cd) is potent a metallohormone commonly poisonous at very low concentrations and a higher dose of Cd even after a short period of exposure results in severe toxic effects on health. The toxic effects of deliberate Cd exposure in the form of oxide, chloride, and sulfide also result in severe health issues due to cellular and molecular changes [66].
A wide range of NPs such as titanium dioxide (TiO2), Iron oxide (FeO), and Manganese oxide (MnO) have been studied for the effective removal of Cd from contaminated water bodies and provides significant outcomes [67]. The alumina NPs and glycerol-modified alumina NPs exhibited up to 99% of Cd (II) removal efficiency. A nanocomposite synthesized using peanut shell-derived biochar (BC) and the hydrated manganese oxide (HMO) has shown the potential outcome of 4–5 times the effective removal of Cd(II) as compared to the BC. Biogenic copper NPs (BioCuNPs) synthesized using a copper-resistant strain of Shigella flexneri SNT22 for an effective removal of Cd, it exhibited decreased acropetal Cd translocation by 49.62%. CuO NPs synthesized using agro-waste, i.e., orange peel and mint leaves have shown excellent metal adsorption (within 60 min) for Cd along with Pd and Ni [68].
Successful in situ removal of Cd has also been reported using biogenic iron oxide NPs (BioFeO-NPs) fabricated using an endophytic Bacterium Pantoea ananatis. The study also reported that this approach could prevent Cd bioavailability for the plant species MTB have potential application in the remediation of HMs as they can both passively align and actively swim along the magnetic field. Magnetosomes are MTB’s trademark nano-ranged intracellular structures, consisting of magnetic iron-bearing inorganic crystals encased by an organic membrane and serving as dedicated organelles for their magnetotactic lifestyle (Figure 5). MTB can absorb metal ions, including precious metal ions, hence their recovery and recycling is a sustainable way to decontaminate the wastewater from HMs [46]. MTB-based magnetic field technology has high application potential in wastewater treatment due to numerous advantages such as high efficiency, low power, low cost, and no secondary pollution, among others (Table 2). Among preliminary studies, researchers observed the application of MTB in environmental clean-up through metal loading. In these studies, up to 100% separation efficiency was achieved within 24 h. Further, Cd recovery by a sulfate-reducing MTB, Desulfovibrio magneticus RS-1, was investigated by and >95% of Cd at an initial concentration of 1.3 ppm was recovered during the operation [69]. Uncultured MTB from microcosms made gold and silver trapping possible. Thus, the research study showed that the adsorption of Au(III), Cu(II), and Ni(II) ions from aqueous solution by MTB in single and ternary systems had been investigated. These systems are eco-friendly, sustainable, and effective. They can be used on a large scale for the prospect.
Figure 5.
Transmission electron microscope (TEM) images of magnetosomes and the magnetosome membrane. (A) TEM micrograph of a cell of Magnetospirillum magneticum strain AMB-1 deposited onto a Formvar-coated electron microscope grid showing a chain of cuboctahedral magnetosomes. (B) TEM micrograph of an ultrathin section of a cell of “Ca. Magnetoovum mohavensis” showing the magnetosome membrane (arrow) surrounding bullet-shaped magnetite crystals. (C) TEM micrograph of an extracted and purified magnetosome chain from a Magnetococcus marinus MC-1 cell showing prismatic magnetite crystals surrounded by the magnetosome membrane (arrow). (D) Scheme of the hypothesized mechanism of magnetite biomineralization. (E) Model for magnetite biomineralization in Magnetospirillum species [70,71]. Reprinted/adapted with permission from Refs. [70,71]. 2022, Elsevier B.V.
Table 2.
Different consortia of algal bacteria used in wastewater treatment.
2.2. Removal of Dyes
The advanced oxidative wastewater pre-treatment methods yield several toxic by-products and expensive methodology of mineralization. Azo dyes are found to be very resistant to photo induced fading and biodegradation. The previous studies reported the combination of biodegradation and photocatalysis in which photocatalyst (g-C3N4-P25) and photosynthetic bacteria encapsulated in calcium alginate beads removed reactive brilliant red X-3b dye in waste water with efficiency of 94% and reduced the COD by 84.7% [77]. Many of the dyes discharged from the effluent of cosmetics, paper, paint, and tannery industries are non-degradable and hazardous waste for aquatic as well as terrestrial lives. Many important classes of dyes are aromatic halogenated compounds that are non-biodegradable, toxic, carcinogenic, and also mutagenic [38]. Various sustainable practices have been conducted in the past to remove dye instantly from aqueous solutions without any toxic byproducts. One of the approaches among many sustainable approaches is the use of biogenic Pd NPs synthesized by Caldicellulosiruptor saccharolyticus (a species of thermophilic, anaerobic cellulolytic bacterium) for the removal of dye (Methyl orange (MO) and diatrizoate) from water bodies that exhibited degradation efficiency significantly better than the chemically synthesized Pd NPs. The rate of degradation of dye by biogenic Pd NPs is twice that of chemically synthesized PdNPs. Besides, the released product of dye degradation is easily absorbed by the biogenic PdNPs to overcome and suppress the toxic effect [38]. PdNPs produced and dispersed by Caldicellulosiruptor saccharolyticus enhance the degradation of contaminants in water. In the same way, the catalytic efficiency of chemically synthesized and biogenic zinc oxide NPs (ZnO NPs) was compared for the removal of dyes such as methylene blue and reactive black-5 from contaminated water. ZnO NPs synthesized using Pseudochrobactrum sp. C5 indicated up to 95% removal efficiency for various dyes, i.e., methylene blue, brilliant blue R, reactive black 5, reactive red 120, and brilliant yellow, respectively significantly much better than chemically synthesized ZnO NPs 85.4%. Thus, the catalytic efficiency of biogenic ZnO NPs for the effective removal and remediation of dye from the aquatic system was much better than chemically synthesized NPs due to their diminutive particle size and larger surface area. Biogenic synthesis of silver NPs (AgNPs) for the transformation of a synthetic textile dye from the actual wastewater by functional groups capping the NPs and elucidating the crystal structure (Figure 6).
Figure 6.
Silver nanoparticles transformed synthetic textile dye through LC-MS analysis and treated the actual wastewater. And Characterization of biogenic AgNPs by (a) FTIR spectra and (b) XRD analysis to measure the functional groups capping the NPs and to elucidate the crystal structure [78]. Reprinted/adapted with permission from Ref. [78]. 2022, Elsevier B.V.
2.3. Removal of Pharmaceutical and Hospital Wastewater Pollutants
Recently, it was reported that the medical waste and pharmaceutical industry effluents contain many toxic xenobiotics and drug compounds that enter either directly into the aquatic system or through contaminated polluted sites [79]. Several conventional methodologies are used to assess a few common pollutants either qualitatively or quantitatively however, they do not apply to the estimation of complex toxic pollutants and their derivatives. The application of NT for the detection, analysis and remediation of such pollutants has become more convenient. Biogenic manganese oxide NPs (MnO NPs) synthesized using Pseudomonas putida to remove under in situ conditions indicate the maximum removal efficiency for steroids estrone and 7α-ethinylestradiol from the aqueous solution (Bharti et al., 2022). In biomedical waste, the drug molecule Diclofenac is an anti-inflammatory halogenated drug found in contaminated sites, and ozonation techniques are used to degrade these chemicals. However, only the partial removal of drug components occurs along with the release of a considerable number of noxious and mutagenic byproducts. In a study, the synthesis of Pd NPs by utilizing the metal-reducing bacterium Shewanella oneiedensis MR-1 has been helpful in the dehalogenation of aromatic compounds and acts as biogenic nanocatalysts [80]. However, in other studies, the bio-Pd NPs were doped with gold (Au) NPs to enhance their catalytic activity for removing diclofenac present in the hospital effluents wastewater treatment plants. In recent times the use of silver NPs (AgNPs) extracted from filamentous fungi (ascomycetes and imperfect fungi) and other fungal species has shown significant wastewater treatment properties. NPs effectively adhere to the cell membrane of microbial contaminants by damaging the cellular DNA [81]. They increase the cell permeability resulting in the generation of free radicles and reactive oxygen species. Besides, these nano-filters are very cheap to synthesize and have great efficiency in removing the pathogenic microbial load in the water. However, the removal rate of the microbial load was limited up to 4 min post-treatment of the samples. In another experiment a cement-silver nanocomposite concrete pebble was developed, that showed 99% removal of microbial load. Thus, the above-discussed approaches showed the importance of green NPs in the treatment of wastewater.
3. Bioaugmentation and Immobilization of Microbial Cells with Nanomaterials for Enhanced Wastewater Treatment
The debasement of unmanageable particles in the contaminated land and water bodies continues by utilizing a bioaugmentation microorganism. In-situ remediation of chlorinated ethenes in groundwater under anaerobic conditions by Dehalococcoides bacterium is a successful example of bioaugmentation in wastewater treatment. Besides that, other bacterial strains such as Acinetobacter sp. TW and Comamonas testosteroni I2 cause biodegradation of 4-fluoroaniline and 3-chloroaniline from polluted water [82,83]. Nevertheless, the highly effective outcome of bioaugmentation possesses certain limitations such as physiological parameters for the cultivation of microbial cells, and abiotic and biotic stresses (e.g., temperature, pH, lack of nutrients, phage infections, compatibility, and competitiveness) resulting in bioaugmentation failure.
To overcome the abovementioned limitation of immobilization of microbial cells, be a practical approach for stabilizing free-floating cell suspension and wastewater treatment. Immobilization technology is considered a potential solution to overcome the functioning of freely suspended microbial cells by providing a stable surface for adherence and reusability [84]. Various immobilization methods, viz. flocculation, cross-linking, encapsulation in a polymer gel, adsorption on NMs, covalent binding to nanocarriers, and entrapment in NM matrix, have been used for cell caging (Table 3).
Table 3.
Substrates for the Immobilization of non-absorbent and effective removal of pollutants.
The high surface area to volume ratio of NMs provides better sorption of pollutants and biodegradation of pollutants by immobilized microbial cells. Therefore, many studies have focused on NMs for caging, and the immobilization of microorganisms for wastewater treatment indicated significant outcomes [91]. In a study, the calcium alginate-IONPs matrix used to immobilize Phanerochaete chrysosporium cells showed higher biosorption efficiency to remove Pb (II) from wastewater, i.e., 96.03% removal at pH five and 35OC. Subsequently, in other studies, NMs such as chitosan nanofibers, graphene nanosheets, silica NPs, and carbon nanotubes (CNTs) are utilized as matrices for microorganisms’ immobilizations and efficient removal of pollutants from contaminated water (Figure 7). The removal of pharmaceutical compounds by cell-supported palladium NPs and removal of sulfamethoxazole in the Bio-Pt catalyst in an assay for 24 h indicates the growth profiles removal of four pharmaceutical compounds (PhP) for 17β-estradiol and ibuprofen (Figure 8).
Figure 7.
CNT-microbial integrated approach for waste water treatment and bioremediation of pollutants.
Figure 8.
(a) This represents complete work flow removal of pharmaceutical compounds (b–d) TEM images of cell-supported palladium nanoparticles. (e) Removal of sulfamethoxazole by the Bio-Pt catalyst in three consecutive assays. Removal data obtained after 24 h of reaction. The error bars indicate the standard deviations of three independent experiments. The error bars indicate the standard deviations of three independent experiments. (f,g) Profiles of growth and removal of four pharmaceutical compounds (PhP) for 17β-estradiol and ibuprofen. The error bars indicate the standard deviations of three independent cultures [39]. Reprinted/adapted with permission from Ref. [39]. 2022, Elsevier B.V.
4. Integrated Microbial and Nanotechnological Approaches for Wastewater Treatment
4.1. Nanoparticle Integrated Microbial Reactor for the Removal of Pollutants from Wastewater
Biogenic NPs synthesized by microbial cellular machinery is used in micro to macro reactor set-ups to enhance the removal efficiency of noxious and harmful contaminants from the treated effluents (Table 4). Many researchers also studied the stabilization of NPs on the bacterial cell walls and encapsulation technique on silica, polyacrylamide, polyurethane, and zeolites for reactor setups. Usually, the activated sludge used for the wastewater treatment results in effective outcomes for municipal wastewater but limited applicability for the remediation efficiency for industrial non-biodegradable and hazardous contaminants. Zero valent iron (ZVI) NPs are used to remove chlorinated organic compounds, and degradation of organic pollutants is an emerging aspect of wastewater treatment. ZVI NPs used in the bioreactor system with immobilized aerobic microbes to treat industrial wastewater have a double effect on removing pollutants. Nano bimetallic structures act as electron donors, causing partial digestion of the organic compounds to reduce them into non-toxic products by aerobic microorganisms.
Table 4.
Commercialized microbial NPs inbuilt bioreactor for wastewater treatment.
The chlorinated solvents and petroleum hydrocarbons are degraded by granular iron by the dichlorination and oxidation into the chlorinated ethenes and short hydrocarbon chains. The synergistic effect of ZVI-NPs and bioactive components has been utilized to treat azo dye and nitroaromatic chemicals. A bench size experiment to investigate the effect of ZVI reactor followed by batch bioreactor for the biological treatment showed maximum levels of persistent organic products and heavy metals reduction. The BOD and COD level was 96.5% and 86% removal efficiency, along with nitrogen removal up to 52.2 from 35%, respectively. The study concluded that the ZVI reactor pre-treatment followed by the biological treatment compromises the most acceptable option for industrial wastewater purification.
4.2. Microbial Nanofibrous Webs Filters (NFW) for Wastewater Treatment
Another technology used for wastewater treatment is filtration and entrapment of pollutants through the membrane. However, extensive research has been conducted to design cost-effective and highly efficient filters for the treatment through nanotechnological aspects i.e., fabrication of electrospinning nanofibers/nano-webs. The NFW is suitable for the filtration and entrapment of micro to nano-dimension pollutants due to the nanoscale porosity and vast surface area [93]. Thus, wastewater purification and filtration can be enhanced by combining nanofibrous matrix with microbial cells such as bacteria or algae were studied and shown to have significant environmental implications owed significant impacts on environmental applications. In removing dye from wastewater, reusable electrospun CA-NFW immobilized bacterial strains Clavibactermichiganensis, Pseudomonas aeruginosa, and Aeromonas eucrenophila composite efficiently removed 95% of the dye molecules within 24 h.
In a study, a hybrid model of electrospun chitosan nanofiber mats (ECNMs) immobilized algal cells has been utilized to remove nitrates from wastewater. The ECNM-algal matrix is easier to handle, requires small space for cultivation, and shows up to 87% of nitrates removal from wastewater. However, the electrospun cellulose acetate nanofibrous webs (CA-NFW) immobilized ammonium oxidizing bacteria Acinetobacter calcoaceticus STB1 cells for ammonium removal from wastewater (98.5%) in the bacterial. Thus, NFWs are the less volume, more active surface area matrix for the immobilization of suspended free microbial cells and be a cost-effective reactor system for the remediation of toxic pollutants and heavy metals. Moreover, the biofilm of biogenic nanocomposite has high stability and significant activity under environmental stress.
4.3. Synergistic Combined Effect of Nanocomposites and Microbial Fuel Cells in Wastewater Treatment
In MFCs wide range of microbes are utilized as biocatalysts for the treatment of wastewater subsequently with the energy production from organic and inorganic pollutants. The bacterial cell helps in breaking down complex chemicals like acetate, propionate, and butyrate into simpler forms, i.e., H2O and CO2. Thereby the conventional technology for electricity production demand gets reduced by using the energy generated by MFCs. Although the components cost of MFC is much higher and performance is deprived than over all other types of fuel cells, it limits its applicability at the commercial level. Therefore, to reduce the treatment cost and utilization of cost-effective models such as membrane and cathode catalytic methods be the option for commercial-scale studies. The optimization of MFC activity in the material used for the reaction and digestion of substrate is a significant issue. There is a wide range of high catalytic activity materials and their modified forms used for the oxidative reduction reaction and to enhance the conductivity of the electrode surface [21]. NPs are the ultimate alternative material having specific interaction, and greater surface area interacts efficiently with the biological system for the entrapment and digestion of pollutants. Several nanocomposites and nanostructured carbon electrodes showed increased performance of MFCs. In a study, carbon nanotubes (CNT) with Pt electrodes act as a catalyst in MFC, and showed strong electrical conductivity in the COD media due to the electrode’s large surface area and higher catalytic efficiency. As a result, due to its unique features, the cathode catalyst used commercially for Pt in MFCs could be substituted by CNT/Pt. In another study, CNT nanocomposite with polymers such as polypyrrole (PPy) and polyaniline (PA) have been used to enhance microbial adhesion and reduce the NPs toxicity. The MFC anodes coating with CNT nanocomposites provides electrostatically bonded due to the presence of positively charged polycationic polymer. The active sites for microbial adhesion and electrochemical reactions are customized due to the PPy–CNT nanocomposite electrodes with a large surface area for bacterial attachment and biofilm formation for electron transfer to the anode surface. Thus, NM MFCs provides a better opportunity for electricity generation and treatment of wastewater.
4.4. Green Microbial Nanotechnology for Wastewater Treatment
The bioremediation of wastewater through nanotechnological approaches, either by using NPs or combined treatment with microbial cells, results in efficient treatment processes and contaminating removal. The bio machinery, including bioactive micro molecules, nanosized catalytic membranes, nanotubes, nanopowder, nano-sorbents, and nanocatalysts, effectively entrap and remove the pollutants from wastewater, purify the system and improve water quality (Figure 9).
Figure 9.
(a) Organic pollutant remediation using nanoparticles and microorganisms. Nanoparticles can be applied either directly or through adsorption to remove organic contaminants. Thereby facilitate bioremediation by enhancing the growth of microorganisms or by immobilizing contaminants through the production of microbial enzymes. (b) Exopolysaccharides-coated nanoparticle synthesis using algae [94]. Reprinted/adapted with permission from Ref. [94]. 2022, Elsevier B.V.
In the green chemistry for wastewater treatment, algal membrane-based bioreactors with NPs were used as an integrated sustainable remediation and energy production technique. Here, the polluted wastewater bodies provide a nutrient-rich environment, i.e., micronutrients such as vitamins like thiamine and cyanocobalamin and macronutrients such as salts of PO43− and NO3− with NH4+, Na, Ca, and K for the algal growth (Figure 10). Thereby the cultivation of algal cells in wastewater helps to remove the pollutants by adsorbing them [95,96]. There are several approaches for isolating algal biomass, either physically by centrifugation, air floatation, and sedimentation, or chemically by flocculation, nevertheless their higher cost for large-scale treatment. In the modern technology applicability of algal biomass for wastewater treatment and bioactive component production, the researchers have focused on developing integrated microalgae biorefineries (Figure 11). In this ingenuity, an algal-based algal membrane bioreactor (AMBR) for wastewater treatment with advanced modifications has been used to cultivate algal biomass at a high density and maximum absorption of contaminants [97]. In this approach, the maximum recovery of algal biomass with minimum harvesting parameters was obtained concerning the traditional methods. Synthetic polymers such as polysulfone (PSF), polyvinylidene fluoride (PVDF), and polyethersulfone (PES) are used for the fabrication of membranes that are chemically and physically stable [98]. However, a significant drawback in AMBR is membrane fouling, which will reduce the performance due to the deposition of particles or solutes in the membrane pores or the membrane surface. Usually, the hydrophobic membranes used to bind the hydrophobic group present on the microbial cell surface or solute particles causes membrane fouling. Another aspect is that the physicochemical properties of the membrane, such as surface charge, hydrophilicity, and roughness, can all affect the fouling of the reactor’s system [52,56]. The hydrophobic interactions between the pollutants and bioreactor membrane can be reduced by hydrophilic group generation to enhance the surface polarity by chemical or plasma surface coating and incorporating NPs. In a study, the reverse osmosis membrane outer layer of polyvinyl alcohol (PVA) was coated with TiO2, resulting in fouling reduction by introducing self-cleaning through UV irradiation [53]. Similarly, the hydrophilicity of the membrane surface was enhanced with antifouling properties and water flux by blending the PSF hollow fibre membranes (HFMs) with multi-walled carbon nanotubes (MWNTs) [84,85,86,87,88,89,90,91,92,93,94,95,96,97,98,99]. Metallic photocatalysis TiO2 has been investigated for various applications for pollution control systems and self-cleaning surfaces of the reactor system (Cruz et al., 2020). The hydrophilicity of the membrane gets enhanced by Nano-TiO2 due to the hydrophilic nature and high specific surface area for specific binding. Thereby membrane fouling reduces, and permeate flux increases. The TiO2-PVDF hollow fibre membrane with a single head-spinning inbuilt machine AMBR for wastewater treatment showed up to 75% of the free elemental phosphorus and nitrogen recovery, reduced membrane fouling due to the hydrophilic properties of PVDF in AMBRs [100]. Thus, incorporating NPs in AMBR demonstrated an effective model for wastewater recovery and overcoming membrane fouling without any chemical modification of the filter membrane.
Figure 10.
(a) Schematic presentation of simulations of wastewater treatment with microalgae biomass cultivation. (b) Nutrient and energy flow in microalgae-bacteria consortium. (c) Mechanisms of various wastewater treatments using microalgae and bacteria [101]. Reprinted/adapted with permission from Ref. [101]. 2022, Elsevier B.V.
Figure 11.
(a) Simplified schematic of the Environment-Enhancing Energy process for integrated wastewater treatment and biofuel production. (b) Microalgal-based microbial cells-based wastewater treatment and bioH2 production [102]. Reprinted/adapted with permission from Ref. [102]. 2022, Elsevier B.V.
5. Advancements and Future Approaches
With the discovery of advanced materials, including quantum dots, MXenes (metal carbides and nitrides), and borophene, the field of wastewater treatment has been revolutionized [103]. However, quantum dots possess a secondary threat due to possible leaching out into surroundings from treatment assemblies, which is hazardous to both humans and the environment. In contrast, advanced 2D materials such as MXenes, especially titanium carbide, possess excellent adsorption efficiency of around 90% to remove heavy metal ions and radionuclides from wastewater. Although such a remarkable efficiency, MXenes are yet to be adopted in commercial and practical practices due to several associated bottlenecks, including the use of corrosive acids during their fabrication, scalability, stability, and cost of production [20]. These bottlenecks can be easily addressed by adopting sustainable bio-nanotechnology-based routes such as microbial-based reduction of their precursors for fabrication, which will reduce the cost, complexity, and secondary contamination related to their manufacturing.
Furthermore, the plausible adoption of the microbial-based route for the synthesis of MXenes and similar emergent materials anticipates a sustainable, scalable, eco-friendly, and cost-effective approach for their fabrication, which opens new prospects for their wastewater treatment adoption [45]. Most importantly, it addresses the concern of leaching out of NMs into the environment as the green route synthesized NMs exhibit superior biocompatibility and negligible toxicity. Thus, one of the advanced prospects of green microbial bio-nanotechnology is to explore the fabrication of promising emergent NMs in wastewater remediation. Since the materials are in abundance, and the utilization of microbial-based fabrication strategies is significantly less, there is a necessity to explore more microbial-assisted synthesis routes for preventing secondary environmental contamination [51].
Furthermore, the integration of advanced technologies, including internet-of-things (IoTs), artificial intelligence (AI), machine learning, cloud computing, and 5G communication with bio-nanotechnology-based water purification strategies, possess the potential to transform the conventional time-consuming and human resources consuming strategies [104]. The connectivity of wastewater treatment systems with advanced communication networks and IoTs, can be used for real-time monitoring and point-of-detection module. By training the systems using pre-analyzed algorithms and AI, the specific water contaminant can be detected, and a point-of-solution module can be devised employing a particular anti-contaminant NM. AI can be further used to explore the various microorganisms and their bio-reductants to fabricate various classes of NMs without undergoing actual experimental studies [105]. Hence, the integration of modern-day technologies with bio-nanotechnology and internet-of-nano-things possesses the potential to revolutionize the present-day water treatment strategies to meet global demand and sustainable development goals of clean water and hygiene (Figure 12). More research in this area is needed to isolate other MTB candidates and better understand the process of magnetosome formation and its role in pollutant removal from water bodies. If these challenges are overcome, MTBs will undoubtedly drive future nanotechnology advancements.
Figure 12.
Future prospects of microbial based water treatment strategies.
6. Conclusions and Outlook
This review explores various microbial nanotechnology-based strategies for wastewater remediation by removing a wide range of organic and inorganic contaminants. Microbial-assisted green NMs have exhibited remarkable absorption and removal efficacy towards recalcitrant and hazardous pollutants due to their high effective surface area, tunable physicochemical attributes, controllable variable morphology, superior regenerative capacities, and excellent performance biocompatibility, peculiar durability, and small intra-particular diffusion range. The utilization of microorganisms in the fabrication of NMs reduces the chemical load in the manufacturing process, and the biochemical involved act as reducing, capping and stabilizing agents. These microbial-assisted NMs exhibit superior adsorptive and catalytic efficiency than NMs fabricated using traditional chemical strategies. Although the notion of bioremediation by microbial NMs has been exhaustively evidenced, numerous formidable factors such as their scalable production, their stability for prolonged utilization, and lower exploration obstruct their commercial development for wastewater treatment. However, these issues have been addressed by adopting alternative strategies, including the immobilization of microbial cells on NM matrix and integrating NT with other green technologies such as algal-based membrane bioreactors, microbial fuel cells, aerobic digesters, and electrospun nanofiber webs. Exploring these alternative techniques is yet to be explored at a large scale with dedicated efforts to develop for commercial prospects.
Besides the commonly used microbes, MTB having nano-ranged intracellular structures has been studied for bio-mineralization. The application of immobilized cells and biogenic NPs in the bioreactor system provides an integrated system for the remediation and energy production from the contaminated effluents as a cost-effective approach with a significant outcome. Hence, based on this review and studies, in the future treatment strategies can be designed for the large sample bioremediation and clean-sustainable technology model designing.
Furthermore, additional studies are required to optimize bio-fabrication procedures concerning economic viability, culture, and handling of microorganisms. The integration of modern-day advanced technologies, including IoT, AI, 5G communication, and cloud computing with bio-nanotechnology-based green NMs is the near future of wastewater treatment strategies to meet the global concern of drinking water scarcity.
Author Contributions
Conceptualization, S.M., A.D., S.P., S.P.B. and T.M.; methodology, A.R. and R.K.S.; software, V.C. and R.K.S.; validation, H.S.J., Y.K.M., V.D.R. and A.K.; formal analysis, A.K.; investigation, S.M., A.D. and S.P.; data curation, S.M., A.D. and S.P.B.; writing—original draft preparation, S.M., A.D., T.M., S.P., J.B. and S.P.B.; writing—review and editing, A.R., R.K.S., V.C. and R.K.S.; visualization, S.M., Y.K.M., V.D.R. and A.K.; supervision, H.S.J., Y.K.M., V.D.R. and A.K.; project administration, S.M., Y.K.M., V.D.R. and A.K.; funding acquisition, H.S.J., Y.K.M., V.D.R. and A.K. All authors have read and agreed to the published version of the manuscript.
Funding
This research received no external funding.
Data Availability Statement
Not applicable.
Conflicts of Interest
The authors declare no conflict of interest.
Abbreviations
| AAS | Atomic Absorption Spectroscopy |
| AgNPs | Silver NPs |
| AMBR | Algal Membrane Bioreactor |
| CA-NFW | Cellulose Acetate Nanofibrous Webs |
| CNT | Carbon Nanotube |
| CrNPs | Chromium NPs |
| ECNM | Electrospun Chitosan Nanofiber Mats |
| EDS | Energy Dispersive Spectroscopy |
| EDX | Energy-dispersive X-ray spectroscopy |
| FTIR | Fourier-Transform Infrared Spectroscopy |
| HPLC | High-Performance Liquid Chromatography |
| MDNPs | Manganese Dioxide NPs |
| MFC | Microbial Fuel Cell |
| NT | Nanotechnology |
| NPs | Nanoparticals |
| NMs | Nanomaterials |
| PdNPs | Palladium NPs |
| IONPs | Iron Oxide NPs |
| PES | polyethersulfone |
| PSF | polysulfone |
| PVA | Polyvinyl Alcohol |
| PVDF | polyvinylidene fluoride |
| SEM | Scanning Electron Microscopy |
| TEM | Transmission Electron Microscopy |
| VSM | Vibrating Sample Magnetometer |
| XPS | X-ray Photoelectron Spectroscopy |
| XRD | X Ray Diffraction |
| ZnONPs | Zinc Oxide NPs |
| ZVI | Zero valent iron |
References
- Yadav, V.K.; Gupta, N.; Kumar, P.; Dashti, M.G.; Tirth, V.; Khan, S.H.; Yadav, K.K.; Islam, S.; Choudhary, N.; Algahtani, A.; et al. Recent Advances in Synthesis and Degradation of Lignin and Lignin Nanoparticles and Their Emerging Applications in Nanotechnology. Materials 2022, 15, 953. [Google Scholar] [CrossRef] [PubMed]
- Jain, K.; Patel, A.; Pardhi, V.; Flora, S. Nanotechnology in wastewater management: A new paradigm towards wastewater treatment. Molecules 2021, 26, 1797. [Google Scholar] [CrossRef] [PubMed]
- Kubiak, K.; Błaszczyk, M.; Sierota, Z.; Tkaczyk, M.; Oszako, T. Slow sand filtration for elimination of phytopathogens in water used in forest nurseries. Scand. J. For. Res. 2015, 30, 664–677. [Google Scholar] [CrossRef]
- Landowski, M.; Imielinska, K. Degradation of GFRP Marine Laminates with Nano Particle Modified Coatings. Adv. Mater. Sci. 2013, 13, 19–22. [Google Scholar] [CrossRef][Green Version]
- Bhat, S.A.; Sher, F.; Hameed, M.; Bashir, O.; Kumar, R.; Vo, D.-V.N.; Ahmad, P.; Lima, E.C. Sustainable nanotechnology based wastewater treatment strategies: Achievements, challenges and future perspectives. Chemosphere 2022, 288, 132606. [Google Scholar] [CrossRef]
- Ma, W.; Cao, W.; Lu, T.; Xiong, R.; Huang, C. Multifunctional nanofibrous membrane fabrication by a sacrifice template strategy for efficient emulsion oily wastewater separation and water purification. J. Environ. Chem. Eng. 2022, 10, 108908. [Google Scholar] [CrossRef]
- Ma, W.; Jiang, Z.; Lu, T.; Xiong, R.; Huang, C. Lightweight, elastic and superhydrophobic multifunctional nanofibrous aerogel for self-cleaning, oil/water separation and pressure sensing. Chem. Eng. J. 2022, 430, 132989. [Google Scholar] [CrossRef]
- Ma, W.; Ding, Y.; Li, Y.; Gao, S.; Jiang, Z.; Cui, J.; Huang, C.; Fu, G. Durable, self-healing superhydrophobic nanofibrous membrane with self-cleaning ability for highly-efficient oily wastewater purification. J. Membr. Sci. 2021, 634, 119402. [Google Scholar] [CrossRef]
- Cao, W.; Ma, W.; Lu, T.; Jiang, Z.; Xiong, R.; Huang, C. Multifunctional nanofibrous membranes with sunlight-driven self-cleaning performance for complex oily wastewater remediation. J. Colloid Interface Sci. 2022, 608, 164–174. [Google Scholar] [CrossRef]
- Mandeep, D.; Shukla, P. Microbial nanotechnology for bioremediation of industrial wastewater. Front. Microbiol. 2020, 11, 590631. [Google Scholar] [CrossRef]
- Bera, S.P.; Godhaniya, M.; Kothari, C. Emerging and advanced membrane technology for wastewater treatment: A review. J. Basic Microbiol. 2022, 62, 245–259. [Google Scholar] [CrossRef] [PubMed]
- Chabalala, M.B.; Gumbi, N.N.; Mamba, B.B.; Al-Abri, M.Z.; Nxumalo, E.N. Photocatalytic Nanofiber Membranes for the Degradation of Micropollutants and Their Antimicrobial Activity: Recent Advances and Future Prospects. Membranes 2021, 11, 678. [Google Scholar] [CrossRef] [PubMed]
- Duo, J.; Li, W.; Wang, Y.; Wang, S.; Wufuer, R.; Pan, X. Photothermal Catalytic Degradation of Lomefloxacin with Nano Au/TiO2. Water 2022, 14, 339. [Google Scholar] [CrossRef]
- Sikiru, S.; Abiodun, O.A.; Sanusi, Y.K.; Sikiru, Y.A.; Soleimani, H.; Yekeen, N.; Haslija, A.A. A comprehensive review on nanotechnology application in wastewater treatment a case study of metal-based using green synthesis. J. Environ. Chem. Eng. 2022, 10, 108065. [Google Scholar] [CrossRef]
- Kakorina, O.A.; Zaporotskova, I.V.; Kakorin, I.A. Detection of impurities in water by using nanostructures. In AIP Conference Proceedings; AIP Publishing LLC: Melville, NY, USA, 2022; Volume 2466. [Google Scholar]
- Kaminski, A.; Edwards, C.; Chrapusta-Srebrny, E.; Lawton, L.A. Anatoxin-a degradation by using titanium dioxide. Sci. Total Environ. 2021, 756, 143590. [Google Scholar] [CrossRef]
- Razack, S.A.; Duraiarasan, S. A way to create a sustainable environment: Green nanotechnology–with an emphasis on noble metals. In The ELSI Handbook of Nanotechnology: Risk, Safety, ELSI and Commercialization; Hussain, C.M., Ed.; Wiley-Scrivener: Austin, TX, USA, 2020; pp. 359–425. [Google Scholar]
- Khan, S. Green Materials for Wastewater Treatment; Springer: Berlin/Heidelberg, Germany, 2020. [Google Scholar]
- Nahak, B.K.; Preetam, S.; Sharma, D.; Shukla, S.; Syväjärvi, M.; Toncu, D.-C.; Tiwari, A. Advancements in net-zero pertinency of lignocellulosic biomass for climate neutral energy production. Renew. Sustain. Energy Rev. 2022, 161, 112393. [Google Scholar] [CrossRef]
- Goutam, S.P.; Saxena, G.; Roy, D.; Yadav, A.K.; Bharagava, R.N. Green synthesis of nanoparticles and their applications in water and wastewater treatment, in Bioremediation of industrial waste for environmental safety. In Bioremediation of Industrial Waste for Environmental Safety; SaxenaRam, G., Bharagava, N., Eds.; Springer: Singapore, 2020; pp. 349–379. [Google Scholar]
- Sivaraj, R.; Salam, H.A.; Rajiv, P.; Rajendran, V. Green nanotechnology: The solution to sustainable development of environment. In Environmental Sustainability; Springer: Berlin/Heidelberg, Germany, 2015; pp. 311–324. [Google Scholar]
- Nahak, B.K.; Mishra, A.; Preetam, S.; Tiwari, A. Advances in Organ-on-a-Chip Materials and Devices. ACS Appl. Bio Mater. 2022, 5, 3576–3607. [Google Scholar] [CrossRef]
- Preetam, S.; Nahak, B.K.; Patra, S.; Toncu, D.C.; Park, S.; Syväjärvi, M.; Orive, G.; Tiwari, A. Emergence of microfluidics for next generation biomedical devices. Biosens. Bioelectron. X 2022, 10, 100106. [Google Scholar] [CrossRef]
- Basheer, A.A. New generation nano-adsorbents for the removal of emerging contaminants in water. J. Mol. Liq. 2018, 261, 583–593. [Google Scholar] [CrossRef]
- Teye, G.K.; Darkwah, W.K.; Jingyu, H.; Ke, L.; Li, Y. Photodegradation of pharmaceutical and personal care products (PPCPs) and antibacterial activity in water by transition metals. Rev. Environ. Contam. Toxicol. 2020, 254, 131–162. [Google Scholar]
- Raja, R.K.; Hazir, S.; Balasubramani, G.; Sivaprakash, G.; Obeth, E.S.J.; Boobalan, T.; Pugazhendhi, A.; Raj, R.H.K.; Arun, A. Green nanotechnology for the environment. In Handbook of Microbial Nanotechnology; Elsevier: Amsterdam, The Netherlands, 2022; pp. 461–478. [Google Scholar]
- Ciambelli, P.; Guardia, G.L.; Vitale, L. Nanotechnology for green materials and processes. In Studies in Surface Science and Catalysis; Elsevier: Amsterdam, The Netherlands, 2020; pp. 97–116. [Google Scholar]
- Han, Y.; Lian, F.; Xiao, Z.; Gu, S.; Cao, X.; Wang, Z.; Xing, B. Potential toxicity of nanoplastics to fish and aquatic invertebrates: Current understanding, mechanistic interpretation, and meta-analysis. J. Hazard. Mater. 2021, 427, 127870. [Google Scholar] [CrossRef] [PubMed]
- Slama, H.B.; Chenari Bouket, A.; Pourhassan, Z.; Alenezi, F.N.; Silini, A.; Cherif-Silini, H.; Oszako, T.; Luptakova, L.; Golińska, P.; Belbahri, L. Diversity of Synthetic Dyes from Textile Industries, Discharge Impacts and Treatment Methods. Appl. Sci. 2021, 11, 6255. [Google Scholar] [CrossRef]
- Yadav, V.; Ali, J.; Garg, M.C. Biosorption of methylene blue dye from textile-industry wastewater onto sugarcane bagasse: Response surface modeling, isotherms, kinetic and thermodynamic modeling. J. Hazard. Toxic Radioact. Waste 2021, 25, 04020067. [Google Scholar] [CrossRef]
- Alsawy, T.; Rashad, E.; El-Qelish, M.; Mohammed, R.H. A comprehensive review on the chemical regeneration of biochar adsorbent for sustainable wastewater treatment. Npj Clean Water 2022, 5, 1–21. [Google Scholar] [CrossRef]
- Mahanty, S.; Bakshi, M.; Ghosh, S.; Chatterjee, S.; Bhattacharyya, S.; Das, P.; Das, S.; Chaudhuri, P. Green synthesis of iron oxide nanoparticles mediated by filamentous fungi isolated from Sundarban mangrove ecosystem, India. BioNanoScience 2019, 9, 637–651. [Google Scholar] [CrossRef]
- Das, P.; Barua, S.; Sarkar, S.; Chatterjee, S.K.; Mukherjee, S.; Goswami, L.; Das, S.; Bhattacharya, S.; Karak, N.; Bhattacharya, S.S. Mechanism of toxicity and transformation of silver nanoparticles: Inclusive assessment in earthworm-microbe-soil-plant system. Geoderma 2018, 314, 73–84. [Google Scholar] [CrossRef]
- Grandmontagne, D.; Navarro, D.; Neugnot-Roux, V.; Ladevèze, S.; Berrin, J.-G. The Secretomes of Aspergillus japonicus and Aspergillus terreus Supplement the Rovabio® Enzyme Cocktail for the Degradation of Soybean Meal for Animal Feed. J. Fungi 2021, 7, 278. [Google Scholar] [CrossRef]
- Gao, W.; Pei, A.; Dong, R.; Wang, J. Catalytic Iridium-Based Janus Micromotors Powered by Ultralow Levels of Chemical Fuels. J. Am. Chem. Soc. 2014, 136, 2276–2279. [Google Scholar] [CrossRef]
- Sayadi, M.H.; Salmani, N.; Heidari, A.; Rezaei, M.R. Bio-synthesis of palladium nanoparticle using Spirulina platensis alga extract and its application as adsorbent. Surf. Interfaces 2018, 10, 136–143. [Google Scholar] [CrossRef]
- Xiao, X.; Ma, X.-B.; Yuan, H.; Liu, P.-C.; Lei, Y.-B.; Xu, H.; Du, D.-L.; Sun, J.-F.; Feng, Y.-J. Photocatalytic properties of zinc sulfide nanocrystals biofabricated by metal-reducing bacterium Shewanella oneidensis MR-1. J. Hazard. Mater. 2015, 288, 134–139. [Google Scholar] [CrossRef]
- Ahmed, S.F.; Mofijur, M.; Ahmed, B.; Mehnaz, T.; Mehejabin, F.; Maliat, D.; Hoang, A.T.; Shafiullah, G. Nanomaterials as a sustainable choice for treating wastewater. Environ. Res. 2022, 214, 113807. [Google Scholar] [CrossRef] [PubMed]
- Martins, M.; Mourato, C.; Sanches, S.; Noronha, J.P.; Crespo, M.B.; Pereira, I.A. Biogenic platinum and palladium nanoparticles as new catalysts for the removal of pharmaceutical compounds. Water Res. 2017, 108, 160–168. [Google Scholar] [CrossRef] [PubMed]
- Luz, G.V.D.S.; Barros, K.V.G.; De Araújo, F.V.C.; Da Silva, G.B.; Da Silva, P.A.F.; Condori, R.C.I.; Brasil, L.M. Nanorobotics in drug delivery systems for treatment of cancer: A review. J. Mat. Sci. Eng. A 2016, 6, 167–180. [Google Scholar]
- Furgal, K.M.; Meyer, R.L.; Bester, K. Removing selected steroid hormones, biocides and pharmaceuticals from water by means of biogenic manganese oxide nanoparticles in situ at ppb levels. Chemosphere 2015, 136, 321–326. [Google Scholar] [CrossRef]
- Kishore, S.; Malik, S.; Shah, M.P.; Bora, J.; Chaudhary, V.; Kumar, L.; Sayyed, R.Z.; Ranjan, A. A comprehensive review on removal of pollutants from wastewater through microbial nanobiotechnology-based solutions. Biotech. Gen. Eng. Rev. 2022, 1–26. [Google Scholar] [CrossRef]
- Elgarahy, A.M.; Elwakeel, K.Z.; Akhdhar, A.; Hamza, M.F. Recent advances in greenly synthesized nanoengineered materials for water/wastewater remediation: An overview. Nanotechnol. Environ. Eng. 2021, 6, 1–24. [Google Scholar] [CrossRef]
- Ghotekar, S.; Pansambal, S.; Lin, K.-Y.A.; Pore, D.; Oza, R. Recent Advances in Synthesis of CeVO4 Nanoparticles and Their Potential Scaffold for Photocatalytic Applications. Top. Catal. 2022, 1–15. [Google Scholar] [CrossRef]
- Lichtfouse, E. Environmental chemistry: Green Chemistry and Pollutants in Ecosystems; Springer Science & Business Media: Berlin/Heidelberg, Germany, 2005. [Google Scholar]
- Bora, T.; Dutta, J. Applications of nanotechnology in wastewater Treatment—A review. J. Nanosci. Nanotechnol. 2014, 14, 613–626. [Google Scholar] [CrossRef]
- Bharti, B.; Kumar, R.; Kumar, H.; Li, H.; Zha, X.; Ouyang, F. Advanced applications and current status of green nanotechnology in the environmental industry. In Green Functionalized Nanomaterials for Environmental Applications; Elsevier: Amsterdam, The Netherlands, 2022; pp. 303–340. [Google Scholar]
- More, N.; Verma, A.; Wickramasinghe, D.; Gautam, R.; Navaratna, D.; Jonnada, A.V.P.R.; Bharagava, R.N. Applications of Nanoparticles for Microbial Contaminants and Pathogens Removal from Wastewater. In Nano-Biotechnology for Waste Water Treatment: Theory and Practices; Rai, J.P.N., Saraswat, S., Eds.; Springer International Publishing: Cham, Switzerland, 2022; pp. 213–226. [Google Scholar]
- Yadav, V.K.; Khan, S.H.; Malik, P.; Thappa, A.; Suriyaprabha, R.; Ravi, R.K.; Choudhary, N.; Kalasariya, H.; Gnanamoorthy, G. Microbial Synthesis of Nanoparticles and Their Applications for Wastewater Treatment. In Microbial Biotechnology: Basic Research and Applications; Singh, J., Vyas, A., Wang, S., Prasad, R., Eds.; Springer: Singapore, Singapore, 2020; pp. 147–187. [Google Scholar]
- Sharma, U.; Sharma, J.G. Nanotechnology for the bioremediation of heavy metals and metalloids. J. Appl. Biol. Biotechnol. 2022, 10, 34–44. [Google Scholar] [CrossRef]
- Bognár, S.; Putnik, P.; Šojić Merkulov, D. Sustainable green nanotechnologies for innovative purifications of water: Synthesis of the nanoparticles from renewable sources. Nanomaterials 2022, 12, 263. [Google Scholar] [CrossRef]
- Ali, I.; Peng, C.; Naz, I.; Khan, Z.M.; Sultan, M.; Islam, T.; Abbasi, I.A. Phytogenic magnetic nanoparticles for wastewater treatment: A review. RSC Adv. 2017, 7, 40158–40178. [Google Scholar] [CrossRef]
- Singh, D.V.; Bhat, R.A.; Dervash, M.A.; Qadri, H.; Mehmood, M.A.; Dar, G.H.; Hameed, M.; Rashid, N. Wonders of nanotechnology for remediation of polluted aquatic environs. In Fresh Water Pollution Dynamics and Remediation; Springer: New York, NY, USA, 2020; pp. 319–339. [Google Scholar]
- Nath, D.; Banerjee, P. Green nanotechnology–a new hope for medical biology. Environ. Toxicol. Pharmacol. 2013, 36, 997–1014. [Google Scholar] [CrossRef] [PubMed]
- Ahmad, S.; Munir, S.; Zeb, N.; Ullah, A.; Khan, B.; Ali, J.; Bilal, M.; Omer, M.; Alamzeb, M.; Salman, S.M.; et al. Green nanotechnology: A review on green synthesis of silver nanoparticles—An ecofriendly approach. Int. J. Nanomed. 2019, 14, 5087. [Google Scholar] [CrossRef] [PubMed]
- Ali, I. New generation adsorbents for water treatment. Chem. Rev. 2012, 112, 5073–5091. [Google Scholar] [CrossRef] [PubMed]
- Kanchi, S.; Ahmed, S. Green Metal Nanoparticles: Synthesis, Characterization and their Applications; John Wiley & Sons: New York, NY, USA, 2018. [Google Scholar]
- Iavicoli, I.; Leso, V.; Ricciardi, W.; Hodson, L.L.; Hoover, M.D. Opportunities and challenges of nanotechnology in the green economy. Environ. Health 2014, 13, 1–11. [Google Scholar] [CrossRef] [PubMed]
- Al-Qahtani, K.M. Cadmium removal from aqueous solution by green synthesis zero valent silver nanoparticles with Benjamina leaves extract. Egypt. J. Aquat. Res. 2017, 43, 269–274. [Google Scholar] [CrossRef]
- Mahanty, S.; Tudu, P.; Ghosh, S.; Chatterjee, S.; Das, P.; Bhattacharyya, S.; Das, S.; Acharya, K.; Chaudhuri, P. Chemometric study on the biochemical marker of the manglicolous fungi to illustrate its potentiality as a bio indicator for heavy metal pollution in Indian Sundarbans. Mar. Pollut. Bull. 2021, 173, 113017. [Google Scholar] [CrossRef]
- Lim, C.K.; Bay, H.H.; Aris, A.; Majid, Z.A.; Ibrahim, Z. Biosorption and biodegradation of Acid Orange 7 by Enterococcus faecalis strain ZL: Optimization by response surface methodological approach. Environ. Sci. Pollut. Res. 2013, 20, 5056–5066. [Google Scholar] [CrossRef]
- Dell’Anno, F.; Rastelli, E.; Buschi, E.; Barone, G.; Beolchini, F.; Dell’Anno, A. Fungi Can Be More Effective than Bacteria for the Bioremediation of Marine Sediments Highly Contaminated with Heavy Metals. Microorganisms 2022, 10, 993. [Google Scholar] [CrossRef]
- Wong, S.; Karn, B. Ensuring sustainability with green nanotechnology. Nanotechnology 2012, 23, 290201. [Google Scholar] [CrossRef]
- Makarov, V.V.; Love, A.J.; Sinitsyana, O.V.; Makarova, S.S.; Yaminsky, I.V.; Taliansky, M.E.; Kalinina, N.O. “Green” nanotechnologies: Synthesis of metal nanoparticles using plants. ActaNaturae (Англoязычная Версия) 2014, 6, 35–44. [Google Scholar] [CrossRef]
- Ahmad, S.Z.N.; Salleh, W.N.W.; Ismail, A.F.; Yusof, N.; Yusop, M.Z.M.; Aziz, F. Adsorptive removal of heavy metal ions using graphene-based nanomaterials: Toxicity, roles of functional groups and mechanisms. Chemosphere 2020, 248, 126008. [Google Scholar] [CrossRef] [PubMed]
- Aghalari, Z.; Dahms, H.-U.; Sillanpää, M.; Sosa-Hernandez, J.E.; Parra-Saldívar, R. Effectiveness of wastewater treatment systems in removing microbial agents: A systematic review. Glob. Health 2020, 16, 1–11. [Google Scholar] [CrossRef] [PubMed]
- Agarwal, P.; Gupta, R.; Agarwal, N. Advances in synthesis and applications of microalgal nanoparticles for wastewater treatment. J. Nanotechnol. 2019, 1–9, 1–9. [Google Scholar] [CrossRef]
- Abdelbasir, S.M.; Shalan, A.E. An overview of nanomaterials for industrial wastewater treatment. Korean J. Chem. Eng. 2019, 36, 1209–1225. [Google Scholar] [CrossRef]
- Arakaki, A.; Nakazawa, H.; Nemoto, M.; Mori, T.; Matsunaga, T. Formation of magnetite by bacteria and its application. J. R. Soc. Interface 2008, 5, 977–999. [Google Scholar] [CrossRef] [PubMed]
- Lefèvre, C.T.; Bazylinski, D.A. Ecology, diversity, and evolution of magnetotactic bacteria. Microbiol. Mol. Biol. Rev. 2013, 77, 497–526. [Google Scholar] [CrossRef]
- Yan, L.; Zhang, S.; Chen, P.; Liu, H.; Yin, H.; Li, H. Magnetotactic bacteria, magnetosomes and their application. Microbiol. Res. 2012, 167, 507–519. [Google Scholar] [CrossRef]
- Guieysse, B.; Borde, X.; Muñoz, R.; Hatti-Kaul, R.; Nugier-Chauvin, C.; Patin, H.; Mattiasson, B. Influence of the initial composition of algal-bacterial microcosms on the degradation of salicylate in a fed-batch culture. Biotechnol. Lett. 2002, 24, 531–538. [Google Scholar] [CrossRef]
- Plata-Díaz, A.M.; Zafra-Gómez, J.L.; Pérez-López, G.; López-Hernández, A.M. Alternative management structures for municipal waste collection services: The influence of economic and political factors. Waste Manag. 2014, 34, 1967–1976. [Google Scholar] [CrossRef]
- Wang, M.; Yang, H.; Ergas, S.J.; van der Steen, P. A novel shortcut nitrogen removal process using an algal-bacterial consortium in a photo-sequencing batch reactor (PSBR). Water Res. 2015, 87, 38–48. [Google Scholar] [CrossRef] [PubMed]
- Xu, Y.; Wang, Y.; Yang, Y.; Zhou, D. The role of starvation in biomass harvesting and lipid accumulation: Co-culture of microalgae-bacteria in synthetic wastewater. Environ. Prog. Sustain. Energy 2016, 35, 103–109. [Google Scholar] [CrossRef]
- Cai, Y.; Shen, J.; Yang, C.-W.; Wan, Y.; Tang, H.-L.; Aljarb, A.A.; Chen, C.; Fu, J.-H.; Wei, X.; Huang, K.-W.; et al. Mixed-dimensional MXene-hydrogel heterostructures for electronic skin sensors with ultrabroad working range. Sci. Adv. 2020, 6, eabb5367. [Google Scholar] [CrossRef] [PubMed]
- Zhang, X.; Wu, Y.; Xiao, G.; Tang, Z.P.; Wang, M.Y. Simultaneous photocatalytic and microbial degradation of dye-containing wastewater by a novel g-C3N4-P25/photosynthetic bacteria composite. PLoS ONE 2017, 12, e0172747. [Google Scholar] [CrossRef]
- Ahmed, T.; Noman, M.; Shahid, M.; Niazi, M.B.K.; Hussain, S.; Manzoor, N.; Wang, X.; Li, B. Green synthesis of silver nanoparticles transformed synthetic textile dye into less toxic intermediate molecules through LC-MS analysis and treated the actual wastewater. Environ. Res. 2020, 191, 110142. [Google Scholar] [CrossRef]
- AlMasoud, N.; Alhaik, H.; Almutairi, M.; Houjak, A.; Hazazi, K.; Alhayek, F.; Aljanoubi, S.; Alkhaibari, A.; Alghamdi, A.; Soliman, D.A.; et al. Green nanotechnology synthesized silver nanoparticles: Characterization and testing its antibacterial activity. Green Process. Synth. 2021, 10, 518–528. [Google Scholar] [CrossRef]
- Azeez, L.; Adejumo, A.L.; Lateef, A.; Adebisi, S.A.; Adetoro, R.O.; Adewuyi, S.O.; Tijani, K.O.; Olaoye, S. Zero-valent silver nanoparticles attenuate Cd and Pb toxicities on Moringa oleifera via immobilization and induction of phytochemicals. Plant Physiol. Biochem. 2019, 139, 283–292. [Google Scholar] [CrossRef]
- Novoselov, K.S.; Fal′ko, V.I.; Colombo, L.; Gellert, P.R.; Schwab, M.G.; Kim, K. A roadmap for graphene. Nature 2012, 490, 192–200. [Google Scholar] [CrossRef]
- Atar, N.; Eren, T.; Yola, M.L.; Wang, S. A sensitive molecular imprinted surface plasmon resonance nanosensor for selective determination of trace triclosan in wastewater. Sens. Actuators B Chem. 2015, 216, 638–644. [Google Scholar] [CrossRef]
- Bhattacharjee, R.; Kumar, L.; Mukerjee, N.; Anand, U.; Dhasmana, A.; Preetam, S.; Bhaumik, S.; Sihi, S.; Pal, S.; Khare, T.; et al. The emergence of metal oxide nanoparticles (NPs) as a phytomedicine: A two-facet role in plant growth, nano-toxicity and anti-phyto-microbial activity. Biomed. Pharmacother. 2022, 155, 113658. [Google Scholar] [CrossRef]
- Aqel, A.; Abou El-Nour, K.M.M.; Ammar, R.A.A.; Al-Warthan, A. Carbon nanotubes, science and technology part (I) structure, synthesis and characterisation. Arab. J. Chem. 2012, 5, 1–23. [Google Scholar] [CrossRef]
- De Gusseme, B.; Hennebel, T.; Christiaens, E.; Saveyn, H.; Verbeken, K.; Fitts, J.P.; Boon, N.; Verstraete, W. Virus disinfection in water by biogenic silver immobilized in polyvinylidene fluoride membranes. Water Res. 2011, 45, 1856–1864. [Google Scholar] [CrossRef] [PubMed]
- Fernandez, J.L.A.; Adolphsen, C.; Akay, A.N.; Aksakal, H.; Albacete, J.L.; Alekhin, S.; Allport, P.; Andreev, V.; Appleby, R.B.; Arikan, E.; et al. A large hadron electron collider at CERN report on the physics and design concepts for machine and detector. J. Phys. G Nucl. Part. Phys. 2012, 39, 075001. [Google Scholar] [CrossRef]
- Hosseini, S.E.; Andwari, A.M.; Wahid, M.A.; Bagheri, G. A review on green energy potentials in Iran. Renew. Sustain. Energy Rev. 2013, 27, 533–545. [Google Scholar] [CrossRef]
- Zhang, H. Ultrathin two-dimensional nanomaterials. ACS Nano 2015, 9, 9451–9469. [Google Scholar] [CrossRef]
- Hou, R.; Chen, X.; Gao, Y.; Zhu, H.; Li, S.; Li, H.; Huo, Y. Synergistic Photocatalysis-Catalytic Peroxidation of BiOBr/H2O2 System for 4-Chlorophenol Degradation. ChemistrySelect 2016, 1, 1000–1003. [Google Scholar] [CrossRef]
- Alanazi, H.S.; Alotaibi, H.; Al-Shehri, H.S.; Alharthi, F.A. Green Synthesis of NiO Nanoparticle Using Ziziphus Spina-Christi Leaves Extract for Photocatalytic Methylene Blue Dye Degradation. Sci. Adv. Mater. 2021, 13, 1756–1763. [Google Scholar] [CrossRef]
- Arora, B.; Attri, P. Carbon nanotubes (CNTs): A potential nanomaterial for water purification. J. Compos. Sci. 2020, 4, 135. [Google Scholar] [CrossRef]
- Martinelli, L.; Nikel, P.I. Breaking the state-of-the-art in the chemical industry with new-to-Nature products via synthetic microbiology. Microb. Biotechnol. 2019, 12, 187. [Google Scholar] [CrossRef]
- Mostafa, M.K.; Mahmoud, A.S.; SaryEl-deen, R.A.; Peters, R.W. Application of entrapped nano zero valent iron into cellulose acetate membranes for domestic wastewater treatment. In Proceedings of the Environmental Aspects, Applications and Implications of Nanomaterials and Nanotechnology 2017–Topical Conference at the 2017 AIChE Annual Meeting, Minneapolis, MN, USA, 1 November 2017. [Google Scholar]
- Bhatt, P.; Pandey, S.C.; Joshi, S.; Chaudhary, P.; Pathak, V.M.; Huang, Y.; Wu, X.; Zhou, Z.; Chen, S. Nanobioremediation: A sustainable approach for the removal of toxic pollutants from the environment. J. Hazard. Mater. 2022, 427, 128033. [Google Scholar] [CrossRef]
- Medina-Cruz, D.; Mostafavi, E.; Vernet-Crua, A.; Cheng, J.; Shah, V.; Cholula-Diaz, J.L.; Guisbiers, G.; Tao, J.; García-Martín, J.M.; Webster, T.J. Green nanotechnology-based drug delivery systems for osteogenic disorders. Expert Opin. Drug Deliv. 2020, 17, 341–356. [Google Scholar] [CrossRef]
- Preetam, S.; Dash, L.; Sarangi, S.S.; Sahoo, M.M.; Pradhan, A.K. Application of Nanobiosensor in Health Care Sector. In Bio-Nano Interface; Springer: Berlin/Heidelberg, Germany, 2022; pp. 251–270. [Google Scholar]
- Hamida, R.S.; Ali, M.A.; Redhwan, A.M.O.; Bin-Meferij, M.M. Cyanobacteria–a promising platform in green nanotechnology: A review on nanoparticles fabrication and their prospective applications. Int. J. Nanomed. 2020, 15, 6033. [Google Scholar] [CrossRef] [PubMed]
- Reverberi, A.P.; Varbanov, P.S.; Vocciante, M.; Fabiano, B. Bismuth oxide-related photocatalysts in green nanotechnology: A critical analysis. Front. Chem. Sci. Eng. 2018, 12, 878–892. [Google Scholar] [CrossRef]
- Yin, J.; Zhu, G.; Deng, B. Multi-walled carbon nanotubes (MWNTs)/polysulfone (PSU) mixed matrix hollow fiber membranes for enhanced water treatment. J. Membr. Sci. 2013, 437, 237–248. [Google Scholar] [CrossRef]
- Verma, A.; Gautam, S.P.; Bansal, K.K.; Prabhakar, N.; Rosenholm, J.M. Green nanotechnology: Advancement in phytoformulation research. Medicines 2019, 6, 39. [Google Scholar] [CrossRef]
- Ho, S.-H.; Chen, Y.-D.; Qu, W.-Y.; Liu, F.-Y.; Wang, Y. Algal culture and biofuel production using wastewater. In Biofuels from Algae; Elsevier: Amsterdam, The Netherlands, 2019; pp. 167–198. [Google Scholar]
- Zhou, Y.; Schideman, L.; Yu, G.; Zhang, Y. A synergistic combination of algal wastewater treatment and hydrothermal biofuel production maximized by nutrient and carbon recycling. Energy Environ. Sci. 2013, 6, 3765–3779. [Google Scholar] [CrossRef]
- Gao, Z.; Raza, R.; Zhu, B.; Mao, Z.Q.; Wang, C.; Liu, Z.X. Preparation and characterization of Sm0.2Ce0.8O1.9/Na2CO3 nanocomposite electrolyte for low-temperature solid oxide fuel cells. Int. J. Hydrog. Energy 2011, 36, 3984–3988. [Google Scholar] [CrossRef]
- Neupane, G.P.; Ma, W.; Yildirim, T.; Tang, Y.; Zhang, L.; Lu, Y. 2D organic semiconductors, the future of green nanotechnology. Nano Mater. Sci. 2019, 1, 246–259. [Google Scholar] [CrossRef]
- Dutta, D.; Das, B.M. Scope of green nanotechnology towards amalgamation of green chemistry for cleaner environment: A review on synthesis and applications of green nanoparticles. Environ. Nanotechnol. Monit. Manag. 2021, 15, 100418. [Google Scholar] [CrossRef]
Publisher’s Note: MDPI stays neutral with regard to jurisdictional claims in published maps and institutional affiliations. |
© 2022 by the authors. Licensee MDPI, Basel, Switzerland. This article is an open access article distributed under the terms and conditions of the Creative Commons Attribution (CC BY) license (https://creativecommons.org/licenses/by/4.0/).